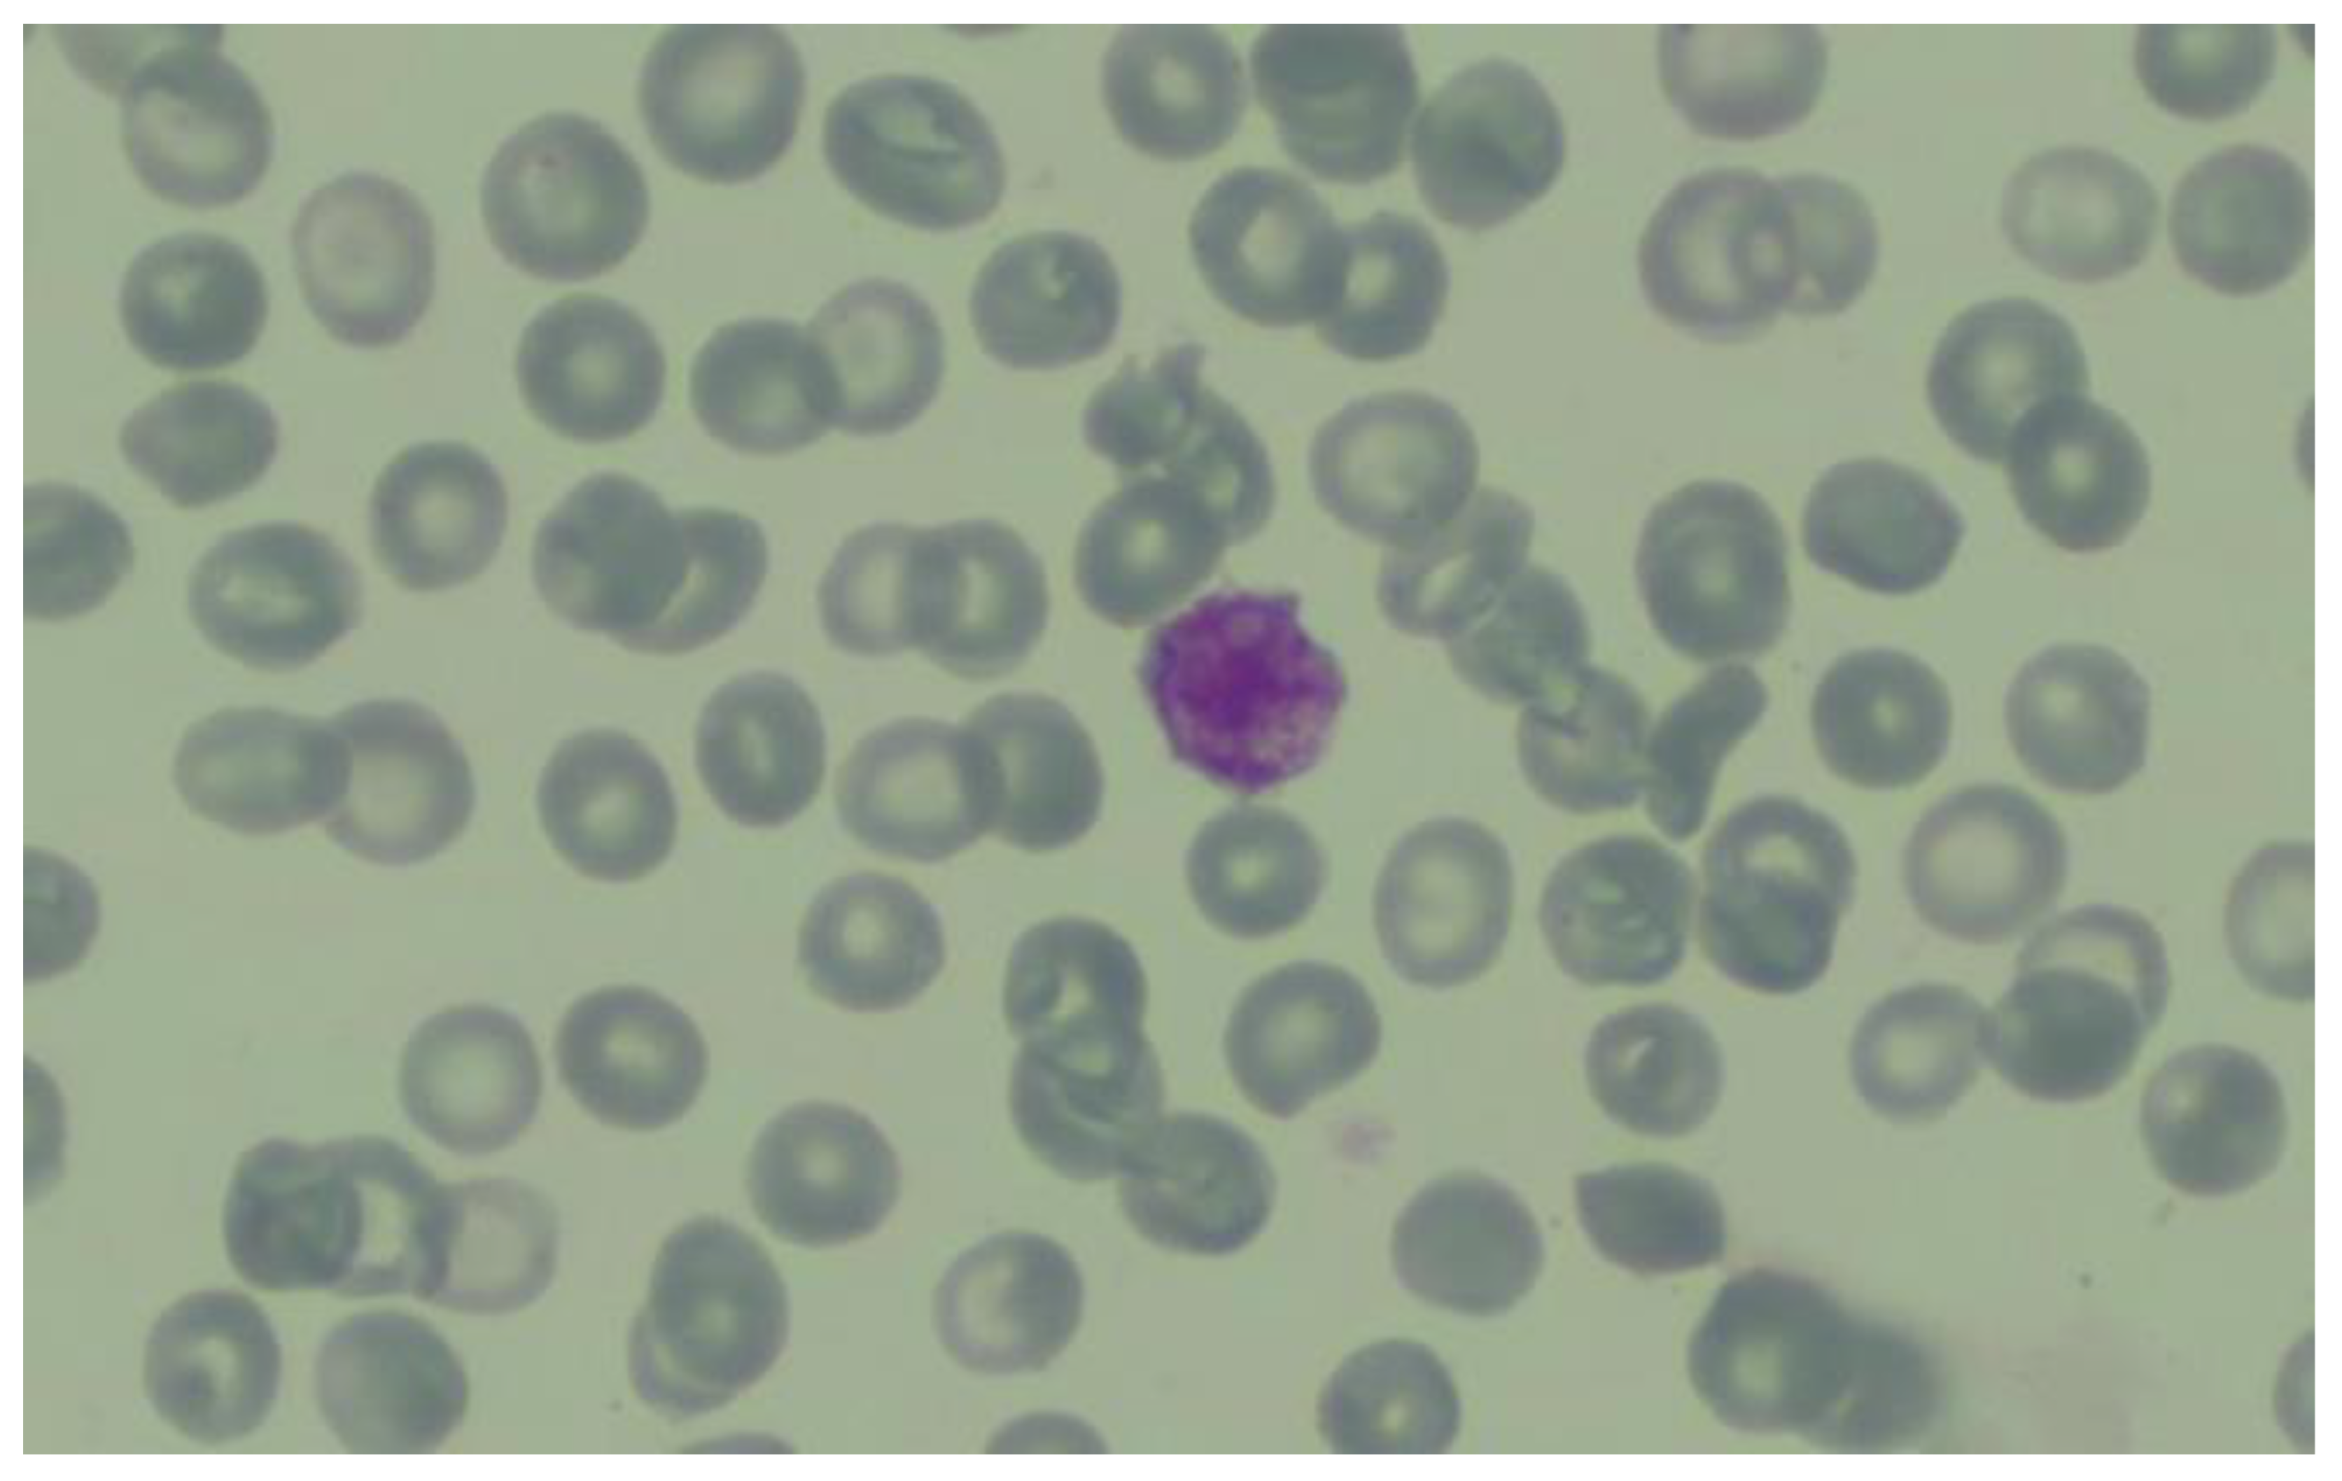
Life 14 01124 g006

Postoperative Thrombocytopenia after Revision Arthroplasty: Features, Diagnostic and Therapeutic Considerations
Abstract
1. Introduction
2. Case Presentation
2.1. Surgical Approach and Management
2.2. Surgical Technique and Management of Acetabular Component Revision
2.3. Hematological Evaluation and Investigation
- Classic heparin-induced thrombocytopenia (HIT), characterized by a drop in the number of platelets > 50% and/or thrombosis, occurring 5–10 days after initiation of treatment, was also considered. Patients develop anti-PF4 (platelet factor 4)-heparin antibodies, detectable by heparin enzyme immunoassay (EIA) and/or positive heparin-induced platelet activation test/HIPA assay [17,18]. We have performed a rapid immunological test to identify anti-PF4/heparin complex antibodies, which was negative; the T4 score was also calculated (and yielded the score 1), both findings making heparin-induced thrombocytopenia unlikely. High-specificity testing or functional evaluation of platelet activation were not performed. The use of the 4Ts clinical score in association with the rapid test for heparin-induced thrombocytopenia maintains its usefulness in clinical practice in the situation where it is not possible to perform tests such as EIA or HIPA assay.
- Autoimmune HIT (aHIT), in which the nature of anti-PF4 antibodies could be heparin-dependent or heparin-independent and includes four entities: delayed-onset HIT, persisting (refractory) HIT, heparin “flush” HIT, and fondaparinux-associated HIT. In all these entities, the PF4-dependent EIA test is positive, and the probability of thrombosis is >95% [16,19,20]. In our case, the patient did not receive non-heparin polyanionic pharmaceutical products capable of triggering HIT, nor fondaparinux.
- Post-knee arthroplasty spontaneous HIT characterized by symptomatic venous thrombosis and adrenal hemorrhage/necrosis [21].
- Hemodilution in association with increased consumption of platelets during surgical hemostasis: 30% of patients undergoing hip arthroplasty had a postoperative platelet count <150 × 109/L [4,13]. These cases are physiological and not severe, with counts usually reaching no lower than 100 × 109/L. However, our patient presented severe thrombocytopenia with sudden onset, which could not have been correlated with hemodilution only.
- In the etiology of postoperative hemorrhagic complications, the interaction between platelets and anesthetic agents has been considered, the responsible mechanisms being platelet dysfunction and alteration of platelet membrane receptors. Sevoflurane, halothane, and propofol inhibit platelet function in a reversible dose-dependent manner [22,23]. An antithrombotic effect was also observed in the case of locoregional anesthesia [24]. Isoflurane, enflurane, desflurane, barbiturates, etomidate, opioids, and muscle relaxants seem to have negligible effects on platelets, at therapeutic concentrations [22]. In the present case, this mechanism of thrombocytopenia was excluded, since the patient benefited from spinal anesthesia with bupivacaine.
- Post-transfusion thrombocytopenia (PTT—post-transfusion purpura). For notable blood loss that occurs as a result of major surgery, transfusion of packed erythrocytes, plasma products, and whole blood is often required. In some patients, mild to moderate thrombocytopenia develops after a transfusion of a large quantity of blood or blood products [25]. However, the mechanism standing behind this occurrence is represented by the formation of alloantibodies (following exposure to foreign antigens) and not autoantibodies (that react with self-antigens). Also, our patient required no blood products before being submitted to surgery and was not administered blood products in consequence, demonstrating that this mechanism cannot be incriminated [26].
2.4. Therapeutic Management and Outcome
3. Conclusions
Author Contributions
Funding
Institutional Review Board Statement
Informed Consent Statement
Data Availability Statement
Conflicts of Interest
References
- Skeith, L.; Baumann Kreuziger, L.; Crowther, M.A.; Warkentin, T.E. A practical approach to evaluating postoperative thrombocytopenia. Blood Adv. 2020, 4, 776–783. [Google Scholar] [CrossRef] [PubMed]
- Greinacher, A.; Selleng, K. Thrombocytopenia in the intensive care unit patient. Hematol. Educ. Program. Am. Soc. Hematol. 2010, 2010, 135–143. [Google Scholar] [CrossRef] [PubMed]
- Zachariah, G.; Walczyszyn, B.; Smith, K.; Stoffels, G.; Spaccavento, C.; Levine, R. Characteristics of the post-surgical decrease in platelet counts in orthopedic surgery patients, observations and insights. Hematol. Transfus. Cell Ther. 2023. [Google Scholar] [CrossRef]
- George, J.N.; Woolf, S.H.; Raskob, G.E.; Wasser, J.S.; Aledort, L.M.; Ballem, P.J.; Blanchette, V.S.; Bussel, J.B.; Cines, D.B.; Kelton, J.G.; et al. Idiopathic thrombocytopenic purpura: A practice guideline developed by explicit methods for the American Society of Hematology. Blood 1996, 88, 3–40. [Google Scholar] [CrossRef]
- Mustard, J.F. Changes in the Platelet Levels of Non-transfused Patients Following Surgical Operations. Acta Haematol. 2009, 17, 257–262. [Google Scholar] [CrossRef]
- Dragosloveanu, S.; Petre, M.A.; Cretu, B.; Mihailescu, A.A.; Cergan, R.; Scheau, C. Etiology of Total Knee Arthroplasty Revisions: A Two-Decade Institutional Perspective. Cureus 2024, 16, e55263. [Google Scholar] [CrossRef]
- Klemt, C.; Cohen-Levy, W.B.; Robinson, M.G.; Burns, J.C.; Alpaugh, K.; Yeo, I.; Kwon, Y.M. Can machine learning models predict failure of revision total hip arthroplasty? Arch. Orthop. Trauma Surg. 2023, 143, 2805–2812. [Google Scholar] [CrossRef]
- Dragosloveanu, Ş.; Dragosloveanu, C.D.M.; Stanca, H.T.; Cotor, D.C.; Dragosloveanu, C.I.; Stoica, C.I. A new perspective towards failure of gamma nail systems. Exp. Ther. Med. 2020, 20, 216. [Google Scholar] [CrossRef]
- Descamps, J.; Teissier, V.; Graff, W.; Mouton, A.; Bouché, P.A.; Marmor, S. Managing early complications in total hip arthroplasty: The safety of immediate revision. J. Orthop. Traumatol. 2023, 24, 38. [Google Scholar] [CrossRef]
- McAlindon, T.; Zucker, N.V.; Zucker, M.O. 2007 OARSI recommendations for the management of hip and knee osteoarthritis: Towards consensus? Osteoarthr. Cartil. 2008, 16, 636–637. [Google Scholar] [CrossRef]
- Mornese Pinna, S.; Corcione, S.; Cavallone, E.; Shbaklo, N.; Vita, D.; De Benedetto, I.; Montrucchio, G.; Pasero, D.; Trompeo, A.C.; Costamagna, A.; et al. Epidemiology and Risk Factors for Nosocomial Infections in Left Ventricular Assist Device Recipients. Life 2024, 14, 270. [Google Scholar] [CrossRef] [PubMed]
- Tsantes, A.G.; Parastatidou, S.; Tsantes, E.A.; Bonova, E.; Tsante, K.A.; Mantzios, P.G.; Vaiopoulos, A.G.; Tsalas, S.; Konstantinidi, A.; Houhoula, D.; et al. Sepsis-Induced Coagulopathy: An Update on Pathophysiology, Biomarkers, and Current Guidelines. Life 2023, 13, 350. [Google Scholar] [CrossRef]
- Kurtz, S.; Ong, K.; Lau, E.; Mowat, F.; Halpern, M. Projections of primary and revision hip and knee arthroplasty in the United States from 2005 to 2030. J. Bone Jt. Surg Am. 2007, 89, 780–785. [Google Scholar] [CrossRef]
- Lostak, J.; Gallo, J.; Slavik, L.; Zapletalova, J.; Balaz, L. Monitoring of fibrinolytic system activity with plasminogen, D-dimers and FDP in primary total knee arthroplasty (TKA) after topical, intravenous or combined administration of tranexamic acid. Biomed. Pap. Med. Fac. Univ. Palacky. Olomouc Czech Repub. 2020, 164, 168–176. [Google Scholar] [CrossRef]
- Singh, R.; Gautam, P.; Sharma, C.; Osmolovskiy, A. Fibrin and Fibrinolytic Enzyme Cascade in Thrombosis: Unravelling the Role. Life 2023, 13, 2196. [Google Scholar] [CrossRef] [PubMed]
- Warkentin, T.E. Platelet-activating anti-PF4 disorders: An overview. Semin. Hematol. 2022, 59, 59–71. [Google Scholar] [CrossRef]
- Warkentin, T.E. Thrombocytopenia caused by platelet destruction, hypersplenism, or hemodilution. In Hematology; Elsevier: Amsterdam, The Netherlands, 2018; pp. 1955–1972. [Google Scholar]
- Greinacher, A.; Warkentin, T.E. Thrombotic anti-PF4 immune disorders: HIT, VITT, and beyond. Hematol. Educ. Program. Am. Soc. Hematol. 2023, 2023, 1–10. [Google Scholar] [CrossRef]
- Schönborn, L.; Esteban, O.; Wesche, J.; Dobosz, P.; Broto, M.; Puig, S.R.; Fuhrmann, J.; Torres, R.; Serra, J.; Llevadot, R.; et al. Anti-PF4 immunothrombosis without proximate heparin or adenovirus vector vaccine exposure. Blood 2023, 142, 2305–2314. [Google Scholar] [CrossRef]
- Favaloro, E.J.; Pasalic, L.; Lippi, G. Antibodies against Platelet Factor 4 and Their Associated Pathologies: From HIT/HITT to Spontaneous HIT-Like Syndrome, to COVID-19, to VITT/TTS. Antibodies 2022, 11, 7. [Google Scholar] [CrossRef]
- Warkentin, T.E. Clinical picture of heparin-induced thrombocytopenia (HIT) and its differentiation from non-HIT thrombocytopenia. Thromb. Haemost. 2016, 116, 813–822. [Google Scholar] [CrossRef]
- Kozek-Langenecker, S.A. The effects of drugs used in anaesthesia on platelet membrane receptors and on platelet function. Curr. Drug Targets 2002, 3, 247–258. [Google Scholar] [CrossRef]
- Bozdogan, N.; Madenoglu, H.; Dogru, K.; Yildiz, K.; Kotanoglu, M.S.; Cetin, M.; Boyaci, A. Effects of isoflurane, sevoflurane, and desflurane on platelet function: A prospective, randomized, single-blind, in vivo study. Curr. Ther. Res. Clin. Exp. 2005, 66, 375–384. [Google Scholar] [CrossRef]
- Mentegazzi, F.; Danelli, G.; Ghisi, D.; Tosi, M.; Gennari, A.; Fanelli, G. Locoregional anesthesia and coagulation. Minerva Anestesiol. 2005, 71, 497–499. [Google Scholar]
- Abdallah, R.; Rai, H.; Panch, S.R. Transfusion Reactions and Adverse Events. Clin. Lab. Med. 2021, 41, 669–696. [Google Scholar] [CrossRef]
- Chang, J.C. Review: Postoperative thrombocytopenia: With etiologic, diagnostic, and therapeutic consideration. Am. J. Med. Sci. 1996, 311, 96–105. [Google Scholar] [CrossRef]
- Nagrebetsky, A.; Al-Samkari, H.; Davis, N.M.; Kuter, D.J.; Wiener-Kronish, J.P. Perioperative thrombocytopenia: Evidence, evaluation, and emerging therapies. Br. J. Anaesth. 2019, 122, 19–31. [Google Scholar] [CrossRef]

Disclaimer/Publisher’s Note: The statements, opinions and data contained in all publications are solely those of the individual author(s) and contributor(s) and not of MDPI and/or the editor(s). MDPI and/or the editor(s) disclaim responsibility for any injury to people or property resulting from any ideas, methods, instructions or products referred to in the content. |
© 2024 by the authors. Licensee MDPI, Basel, Switzerland. This article is an open access article distributed under the terms and conditions of the Creative Commons Attribution (CC BY) license (https://creativecommons.org/licenses/by/4.0/).
Share and Cite
Saguna, C.; Berbec, N.M.; Platon, M.; Marcoci, A.; Jercan, A.; Colita, A.; Gherghe, M.E.; Nedelea, D.-G.; Cergan, R.; Scheau, C.; et al. Postoperative Thrombocytopenia after Revision Arthroplasty: Features, Diagnostic and Therapeutic Considerations. Life 2024, 14, 1124. https://doi.org/10.3390/life14091124
Saguna C, Berbec NM, Platon M, Marcoci A, Jercan A, Colita A, Gherghe ME, Nedelea D-G, Cergan R, Scheau C, et al. Postoperative Thrombocytopenia after Revision Arthroplasty: Features, Diagnostic and Therapeutic Considerations. Life. 2024; 14(9):1124. https://doi.org/10.3390/life14091124
Chicago/Turabian StyleSaguna, Carmen, Nicoleta Mariana Berbec, Marian Platon, Alexandra Marcoci, Andreea Jercan, Andrei Colita, Mihai Emanuel Gherghe, Dana-Georgiana Nedelea, Romica Cergan, Cristian Scheau, and et al. 2024. "Postoperative Thrombocytopenia after Revision Arthroplasty: Features, Diagnostic and Therapeutic Considerations" Life 14, no. 9: 1124. https://doi.org/10.3390/life14091124
APA StyleSaguna, C., Berbec, N. M., Platon, M., Marcoci, A., Jercan, A., Colita, A., Gherghe, M. E., Nedelea, D.-G., Cergan, R., Scheau, C., & Dragosloveanu, S. (2024). Postoperative Thrombocytopenia after Revision Arthroplasty: Features, Diagnostic and Therapeutic Considerations. Life, 14(9), 1124. https://doi.org/10.3390/life14091124

